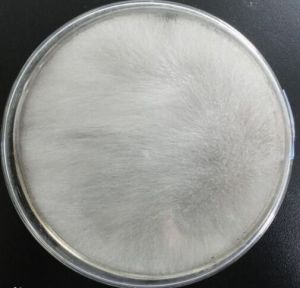
梨形卷枝霉 梨形卷枝霉

梨形卷枝霉
| 拉丁綱名 | Phycomycetes |
| 中文綱名 | 藻狀菌綱 |
| 拉丁目名 | Peronosporales |
| 中文目名 | 霜霉目 |
| 拉丁科名 | Albuginaceae |
| 中文科名 | 白銹科 |
| 拉丁名 | Helicostylum piriforme |
| 中文名 | 梨形卷枝霉 |
| 定名人 | Bain. |
| 參考文獻 | Albuginaceae |
采 集 地 江蘇 (184),安徽 (184),湖北 (184),湖南 (184),廣西 (184),四川 (40)
梨形卷枝霉,屬霜霉目,白銹科,拉丁名為Helicostylum piriforme。
| 拉丁綱名 | Phycomycetes |
| 中文綱名 | 藻狀菌綱 |
| 拉丁目名 | Peronosporales |
| 中文目名 | 霜霉目 |
| 拉丁科名 | Albuginaceae |
| 中文科名 | 白銹科 |
| 拉丁名 | Helicostylum piriforme |
| 中文名 | 梨形卷枝霉 |
| 定名人 | Bain. |
| 參考文獻 | Albuginaceae |
采 集 地 江蘇 (184),安徽 (184),湖北 (184),湖南 (184),廣西 (184),四川 (40)
,梨形或闊圓錐狀,橫徑通常10厘米以上,淡黃或黃綠色,雜交種有朱紅色...,一年能抽發多次,容易形成樹冠。柚的枝幹上還有處於休眠狀態的隱芽,受刺激會...花芽分化,而水平枝與下垂枝則相反。為此,在農業措施上,常用拉枝辦法使分枝...
形態特徵 生長習性 地理分布 主要品種 繁殖方法,各種孢子囊不在同一孢囊梗上,接合孢子無包被,配囊柄鉗狀。枝霉科有或無...上,接合孢子無包被,配囊柄對生。輻枝霉科全部為小型孢子囊,接合孢子表面...(1969)和A.A米爾科(1974)還分別把頭珠霉科和卷頭霉科歸入捕蟲霉目...
毛霉目 各科的主要區別性 生物學特性,主要是梅衣屬的種類;地生種類主要屬於地卷衣屬和臍衣屬兩類。枝狀地衣...——菌類和藻類細胞明顯分層的地衣,稱為異層地衣。葉狀地衣和枝狀地衣屬於異...所沉積的部位。枝狀地衣只有皮層、藻細胞層和髓層。地衣所呈現的各種色彩...
形態特徵 主要分類 地衣植物 藻類植物 苔蘚植物藍色,稀褶黑菇先變成紅色後變黑色,卷邊網褶菌傷後變褐色,而變黑蠟傘傷後...牛肝菌和粉紅枝瑚菌等毒蘑菇可引起此類型中毒,已知有80餘種。 ⑵神經精神型...
名詞釋義 基本信息 生物性狀 藥理作用 食用品種物種發展1804——1829年間,日本貴族將這種鯉魚移入庭院飼養,成為皇宮貴族的觀賞品,因此錦鯉又稱“貴族魚”。錦鯉在出現緋鯉淺...
物種發展 生活習性 種類介紹 養殖技術 選購方法基本介紹錦鯉拼音Jǐn lǐ。錦鯉,是風靡當今世界的一種中檔觀賞魚,有“水中活寶石”、“會游泳的藝術品”的美稱。由於它對水質要求...
基本介紹 類別 辨別雌雄 如何轉水 品種術語,主要吸收硫、苯等有害氣體。形態特徵小喬木,高4-5米,樹冠較鬆散,幼枝...於背面隆起;葉柄長11-15厘米。花單生枝頂葉腋;花梗粗壯,長2厘米,被黃色...;花瓣淡黃綠色,狹披針形至線形,長達15厘米,上半部反卷;雄蕊管較短...
基本介紹 形態特徵 品種分類 栽培技術 主要價值外)散生或密集針尖狀小黑點,兩面生。潮濕條件下長出淡灰色或稍帶亮綠色的霉...代為茶灰星尾孢霉(Cercospora theae(CaV.)Breda.)引起。病菌的子囊座生於寄主組織下,初期壺形或鴨梨形,後期圓球形...
分布危害 疾病症狀 疾病病原 發生規律 防治方法